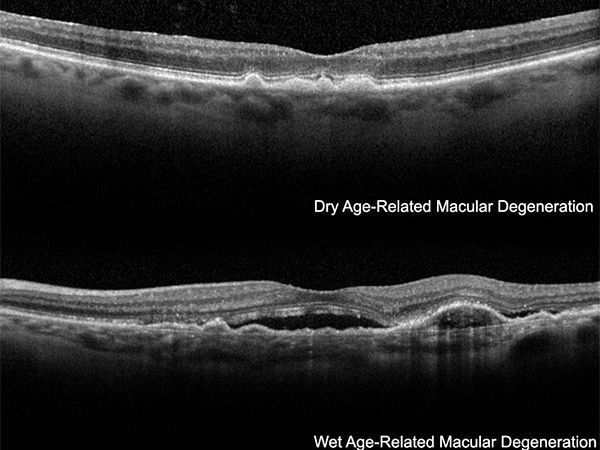

VRMNY DOWNTOWN MANHATTAN Clinic in New York, United States

Top Specialities:
Description
The Downtown ophthalmologists and retina specialists at Vitreous Retina Macula Consultants of New York are internationally known leaders in diagnosing and treating retinal diseases. The VRMNY retina doctors in the Lower Manhattan are world-recognized retina experts in difficult-to-diagnose and rare conditions. They offer the latest treatments for retinal diseases, focusing on treating macular degeneration, diabetic retinopathy, and retinal tears and detachments.
For more information about the Vitreous Retina Macula Consultants of New York, our doctors, or to schedule a consultation with Dr. Richard F. Spaide, please contact our ophthalmology practice by number: (212) 234–3367.
Google map: https://goo.gl/maps/V69qfU2eHGCS8p337
https://plus.codes/87G7PX9X+7J New York
Nearby Service Locations:
Tribeca, New York, NY, USA
Gramercy Park, New York, NY, USA
Ukrainian Village, New York, NY, USA
Alphabet City, New York, NY 10009, USA
Lower East Side, New York, NY, USA
Chinatown, New York, NY, USA
Peter Cooper Village, New York, NY, USA
West Village, New York, NY, USA
Bowery, New York, NY, USA
Greenwich Village, New York, NY, USA
East Village, New York, NY, USA
NoHo, New York, NY, USA
Civic Center, New York, NY, USA
Lower Manhattan, New York, NY, USA
Union Square, New York, NY 10003, USA
SoHo, New York, NY, USA
Seaport, New York, NY 10038, USA
Nearby Service Zip Codes:
10012, 10002, 10013, 10278, 10007, 10282, 10279, 10271, 10038, 10005
Vitreous Retina Macula Consultants of New York
110 Lafayette St, Suite 502
New York, NY 10013
Office Tel # (212) 234–3367
(212) 861–9797
Fax: (212) 628–0698
Web Address: https://www.vrmny.com/
https://www.vrmny.com/locations/downtown-manhattan/
Working Hours:
Monday-Friday: 8am–5pm
Payment: cash, check, credit cards.
Our Services
Our Partners
Medical Tourism Insurance Companies:
Medical Tourism Travel Agencies:
Packages, Promos & Coupons
Official URL
Our Websites
Spoken Languages

Reviews for VRMNY DOWNTOWN MANHATTAN
Very good ophthalmology practice. Always clean. Nice staff. Each ophthalmologist works well with you one on one and gives genuine insight. Highly recommended!